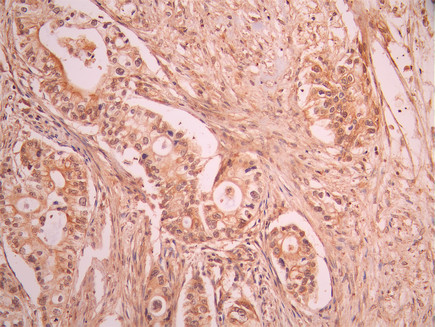
CSB-RA037392A0HU

TRAF6
TRAF6 ,全稱為 TNF 受體相關(guān)因子 6,是一種重要的信號轉(zhuǎn)導(dǎo)蛋白,參與多種細胞因子和炎癥反應(yīng)的調(diào)控。它也被稱為 MGC:3310、RNF85 等。TRAF6 蛋白在免疫系統(tǒng)中發(fā)揮著關(guān)鍵作用,與多種疾病的發(fā)生發(fā)展密切相關(guān)。研究表明,TRAF6 蛋白的異常活化會導(dǎo)致多種人類重大疾病,如成骨樣細胞炎、肝炎、心肌炎、胰腺炎、腸炎、動脈粥樣硬化或相關(guān)腫瘤等。
TRAF6 蛋白通過與多種蛋白結(jié)合,參與多種信號通路。例如,它可以與 ASK1、CD40、FHL2 等蛋白結(jié)合,激活 NFκB 信號通路,進而促進炎癥反應(yīng)。此外,TRAF6 蛋白還參與 TLR 信號通路和 RANKL 信號通路的調(diào)控,影響免疫細胞的活化和趨化。
由于 TRAF6 蛋白在炎癥反應(yīng)中的重要作用,它成為了一種潛在的藥物靶點。目前,已有研究表明,通過抑制 TRAF6 蛋白的活性,可以有效治療多種炎癥性疾病。例如,DRD5 蛋白的激動劑可以抑制 TRAF6 介導(dǎo)的 NFκB 信號通路的激活,從而發(fā)揮抗炎作用。此外,還有研究報道了 MST4 激酶可以調(diào)控 TRAF6 蛋白的活性,進而影響免疫炎癥反應(yīng)。
熱銷產(chǎn)品
Recombinant Human TNF receptor-associated factor 6 (TRAF6) (CSB-EP024154HUe1)
驗證數(shù)據(jù)

(Tris-Glycine gel) Discontinuous SDS-PAGE (reduced) with 5% enrichment gel and 15% separation gel.
TRAF6 Recombinant Monoclonal Antibody (CSB-RA037392A0HU)
驗證數(shù)據(jù)
IHC image of CSB-RA037392A0HU diluted at 1:100 and staining in paraffin-embedded human pancreatic cancer performed on a Leica BondTM system. After dewaxing and hydration, antigen retrieval was mediated by high pressure in a citrate buffer (pH 6.0). Section was blocked with 10% normal goat serum 30min at RT. Then primary antibody (1% BSA) was incubated at 4°C overnight. The primary is detected by a Goat anti-rabbit polymer IgG labeled by HRP and visualized using 0.05% DAB.

Immunofluorescence staining of Hela cell with CSB-RA037392A0HU at 1:50 , counter-stained with DAPI. The cells were fixed in 4% formaldehyde, permeabilized using 0.2% Triton X-100 and blocked in 10% normal Goat Serum. The cells were then incubated with the antibody overnight at 4°C. The secondary antibody was Alexa Fluor 488-congugated AffiniPure Goat Anti-Rabbit IgG(H+L).

Overlay Peak curve showing SH-SY5Y cells stained with CSB-RA037392A0HU (red line) at 1:100. The cells were fixed in 4% formaldehyde and permeated by 0.2% TritonX-100 for 10min. Then 10% normal goat serum to block non-specific protein-protein interactions followed by the antibody (1ug/1*106cells) for 45min at 4℃. The secondary antibody used was FITC-conjugated goat anti-rabbit IgG (H+L) at 1/200 dilution for 35min at 4℃.Control antibody (green line) was Rabbit IgG (1ug/1*106cells) used under the same conditions. Acquisition of >10, 000 events was performed.
TRAF6 Antibody (CSB-PA024154LA01HU)
驗證數(shù)據(jù)

Immunohistochemistry of paraffin-embedded human liver tissue using CSB-PA024154LA01HU at dilution of 1:100

Immunohistochemistry of paraffin-embedded human adrenal gland tissue using CSB-PA024154LA01HU at dilution of 1:100

Immunofluorescence staining of Hela cells with CSB-PA024154LA01HU at 1:333, counter-stained with DAPI. The cells were fixed in 4% formaldehyde, permeabilized using 0.2% Triton X-100 and blocked in 10% normal Goat Serum. The cells were then incubated with the antibody overnight at 4°C. The secondary antibody was Alexa Fluor 488-congugated AffiniPure Goat Anti-Rabbit IgG(H+L).
Human tumor necrosis factor receptor-associated factor 6,TRAF6 ELISA kit (CSB-E14078h)
驗證數(shù)據(jù)

貨號:CSB-E14078h
規(guī)格:96T/48T
靈敏度:9.8 pg/mL
檢測范圍:39 pg/mL-2500 pg/mL
These standard curves are provided for demonstration only. A standard curve should be generated for each set of samples assayed.
TRAF6 Antibodies
TRAF6 for Homo sapiens (Human)
| 產(chǎn)品貨號 | 產(chǎn)品名稱 | 種屬反應(yīng)性 | 應(yīng)用類型 |
|---|---|---|---|
| CSB-PA024154GA01HU | TRAF6 Antibody | Human,Mouse,Rat | ELISA,WB,IHC,IF |
| CSB-PA024154LA01HU | TRAF6 Antibody | Human | ELISA, IHC, IF |
| CSB-PA024154LC01HU | TRAF6 Antibody, FITC conjugated | Human | |
| CSB-PA024154LB01HU | TRAF6 Antibody, HRP conjugated | Human | ELISA |
| CSB-PA004325 | TRAF6 Antibody | Human,Mouse,Rat | WB, IHC, ELISA |
| CSB-PA097438 | TRAF6 Antibody | Human,Mouse,Rat | ELISA,WB,IHC |
| CSB-PA954966 | TRAF6 Antibody | Human,Mouse,Rat | ELISA,WB,IHC |
| CSB-RA037392A0HU | TRAF6 Recombinant Monoclonal Antibody | Human | ELISA, IHC, IF, FC |
TRAF6 Proteins
TRAF6 Proteins for Mus musculus (Mouse)
| 產(chǎn)品貨號 | 產(chǎn)品名稱 | 來源 |
|---|---|---|
| CSB-YP024154MO CSB-EP024154MO CSB-BP024154MO CSB-MP024154MO CSB-EP024154MO-B |
Recombinant Mouse TNF receptor-associated factor 6 (Traf6) | Yeast E.coli Baculovirus Mammalian cell In Vivo Biotinylation in E.coli |
TRAF6 Proteins for Sus scrofa (Pig)
| 產(chǎn)品貨號 | 產(chǎn)品名稱 | 來源 |
|---|---|---|
| CSB-YP024154PI CSB-EP024154PI CSB-BP024154PI CSB-MP024154PI CSB-EP024154PI-B |
Recombinant Pig TNF receptor-associated factor 6 (TRAF6), partial | Yeast E.coli Baculovirus Mammalian cell In Vivo Biotinylation in E.coli |
TRAF6 Proteins for Rattus norvegicus (Rat)
| 產(chǎn)品貨號 | 產(chǎn)品名稱 | 來源 |
|---|---|---|
| CSB-YP024154RA CSB-EP024154RA CSB-BP024154RA CSB-MP024154RA CSB-EP024154RA-B |
Recombinant Rat TNF receptor-associated factor 6 (Traf6) | Yeast E.coli Baculovirus Mammalian cell In Vivo Biotinylation in E.coli |
TRAF6 Proteins for Macaca mulatta (Rhesus macaque)
| 產(chǎn)品貨號 | 產(chǎn)品名稱 | 來源 |
|---|---|---|
| CSB-YP024154MOW CSB-EP024154MOW CSB-BP024154MOW CSB-MP024154MOW CSB-EP024154MOW-B |
Recombinant Macaca mulatta (Rhesus macaque) TNF receptor-associated factor 6 (TRAF6), partial | Yeast E.coli Baculovirus Mammalian cell In Vivo Biotinylation in E.coli |
TRAF6 Proteins for Cercocebus atys (Sooty mangabey) (Cercocebus torquatus atys)
| 產(chǎn)品貨號 | 產(chǎn)品名稱 | 來源 |
|---|---|---|
| CSB-YP024154DRI CSB-EP024154DRI CSB-BP024154DRI CSB-MP024154DRI CSB-EP024154DRI-B |
Recombinant Cercocebus atys TNF receptor-associated factor 6 (TRAF6), partial | Yeast E.coli Baculovirus Mammalian cell In Vivo Biotinylation in E.coli |
TRAF6 Proteins for Danio rerio (Zebrafish) (Brachydanio rerio)
| 產(chǎn)品貨號 | 產(chǎn)品名稱 | 來源 |
|---|---|---|
| CSB-YP024154DIL CSB-EP024154DIL CSB-BP024154DIL CSB-MP024154DIL CSB-EP024154DIL-B |
Recombinant Danio rerio TNF receptor-associated factor 6 (traf6), partial | Yeast E.coli Baculovirus Mammalian cell In Vivo Biotinylation in E.coli |
TRAF6 Proteins for Homo sapiens (Human)
| 產(chǎn)品貨號 | 產(chǎn)品名稱 | 來源 |
|---|---|---|
| CSB-YP024154HU CSB-BP024154HU CSB-MP024154HU CSB-EP024154HU-B |
Recombinant Human TNF receptor-associated factor 6 (TRAF6) | Yeast Baculovirus Mammalian cell In Vivo Biotinylation in E.coli |
| CSB-EP024154HU | Recombinant Human TNF receptor-associated factor 6 (TRAF6) | E.coli |
| CSB-EP024154HUe1 | Recombinant Human TNF receptor-associated factor 6 (TRAF6) | E.coli |
TRAF6 Proteins for Xenopus tropicalis (Western clawed frog) (Silurana tropicalis)
| 產(chǎn)品貨號 | 產(chǎn)品名稱 | 來源 |
|---|---|---|
| CSB-YP024154XBF CSB-EP024154XBF CSB-BP024154XBF CSB-MP024154XBF CSB-EP024154XBF-B |
Recombinant Xenopus tropicalis TNF receptor-associated factor 6 (traf6), partial | Yeast E.coli Baculovirus Mammalian cell In Vivo Biotinylation in E.coli |
TRAF6 Proteins for Bos taurus (Bovine)
| 產(chǎn)品貨號 | 產(chǎn)品名稱 | 來源 |
|---|---|---|
| CSB-YP024154BO CSB-EP024154BO CSB-BP024154BO CSB-MP024154BO CSB-EP024154BO-B |
Recombinant Bovine TNF receptor-associated factor 6 (TRAF6) | Yeast E.coli Baculovirus Mammalian cell In Vivo Biotinylation in E.coli |
TRAF6 ELISA Kit
TRAF6 ELISA Kit for Homo sapiens (Human)
| 產(chǎn)品貨號 | 產(chǎn)品名稱 | 樣本類型 | 靈敏度 |
|---|---|---|---|
| CSB-E14078h | Human tumor necrosis factor receptor-associated factor 6,TRAF6 ELISA kit | serum, plasma, tissue homogenates, cell lysates | 9.8 pg/mL |
















